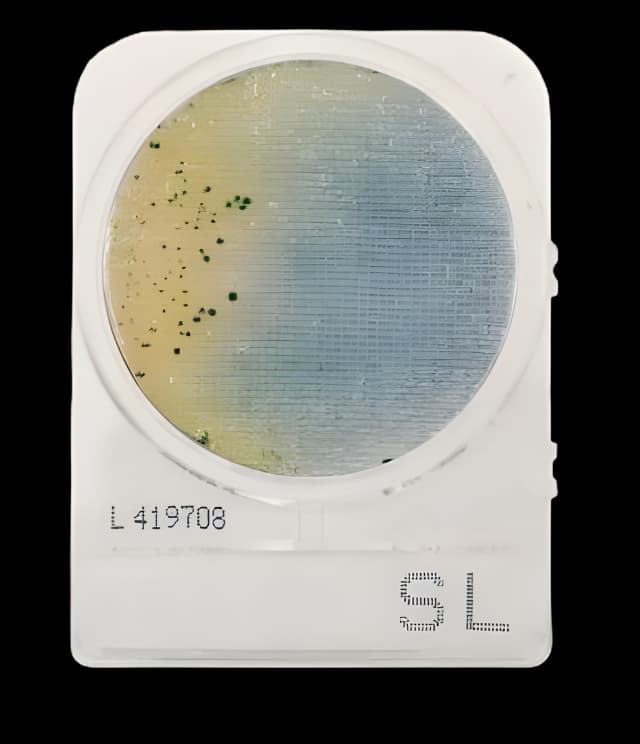
Culture Media CompactDry™ Salmonella Mini Plate

Culture Media CompactDry™ Salmonella Mini Plate
USAMP#29504517SKU: 54085CompactDry™

Product Spotlight
- CompactDry™ SL is recommended for the isolation and differentiation of Salmonella in raw materials, finished products, or on environmental surfaces pertaining to food and related industries
- Each cassette comes with 4 connected plates that can be easily snapped apart to support a variety of dilution scenarios
- Sturdy frame, stackable packaging
- 24 hour result time
- Self-diffusing media
- Ability to subculture without damage to colonies
- Stored at room temperature vs the competitor products with storage at temperatures less than or equal to 8°C
- No leakage
- Easy to label